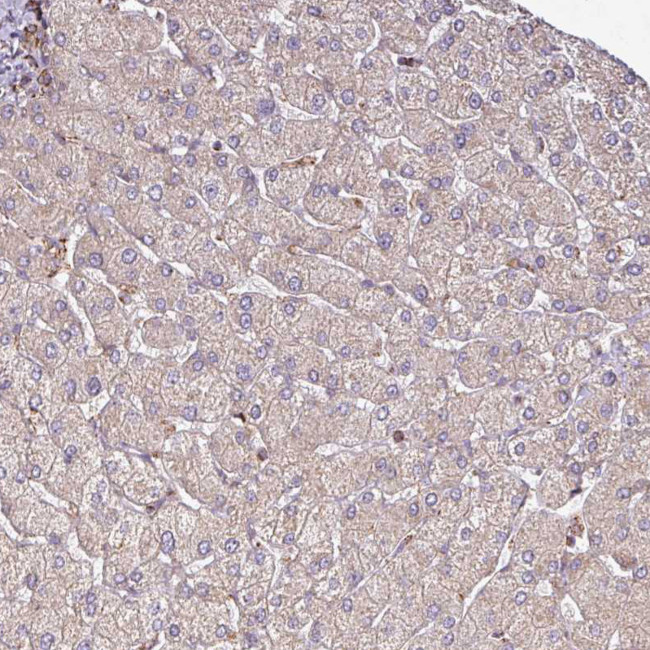
GPD2 Antibody in Immunohistochemistry (Paraffin) (IHC (P))

Search
Invitrogen
GPD2 Polyclonal Antibody
{{$productOrderCtrl.translations['antibody.pdp.commerceCard.promotion.promotions']}}
{{$productOrderCtrl.translations['antibody.pdp.commerceCard.promotion.viewpromo']}}
{{$productOrderCtrl.translations['antibody.pdp.commerceCard.promotion.promocode']}}: {{promo.promoCode}} {{promo.promoTitle}} {{promo.promoDescription}}. {{$productOrderCtrl.translations['antibody.pdp.commerceCard.promotion.learnmore']}}
产品信息
PA5-61022
种属反应
宿主/亚型
分类
类型
抗原
偶联物
形式
浓度
规格
纯化类型
保存液
内含物
保存条件
运输条件
RRID
产品详细信息
Immunogen sequence: TAVDMISRRT RLAFLNVQAA EEALPRIVEL MGRELNWDDY KKQEQLETAR KFLYYEMGYK SRSEQLTDRS EISLLPSDID RYKKRFHKFD ADQKGFITIV DVQRVLESIN VQMDENTL
Highest antigen sequence identity to the following orthologs: Mouse - 90%, Rat - 86%.
靶标信息
Mitochondrial glycerophosphate dehydrogenase (EC 1. 1. 99. 5), or GPD2, is located on the outer surface of the inner mitochondrial membrane and catalyzes the unidirectional conversion of glycerol-3-phosphate (G-3-P) to dihydroxyacetone phosphate (DHAP) with concomitant reduction of the enzyme-bound FAD. Together with a cytosolic NAD-linked GPD (GPD1; MIM 138420), GPD2 forms the glycerol phosphate shuttle, which uses the interconversion of G-3-P and DHAP to transfer reducing equivalents into mitochondria, resulting in the reoxidation of NADH formed during glycolysis.
仅用于科研。不用于诊断过程。未经明确授权不得转售。
篇参考文献 (0)
生物信息学
蛋白别名: glycerol-3-phosphate dehydrogenase 2 (mitochondrial); glycerol-3-phosphate dehydrogenase 2 (mitochondrial) isoform GPD2_1; glycerol-3-phosphate dehydrogenase 2 (mitochondrial) isoform GPD2_2; Glycerol-3-phosphate dehydrogenase, mitochondrial; GPD-M; GPD3; GPDH-M; mGDH; mitochondrial glycerol-3-phosphate dehydrogenase; mitochondrial glycerophosphate dehydrogenase; mitochondrial glycerophosphate dehydrogenase gene; mitohondrial glycerophosphate dehydrogenase; mtGPD; testicular tissue protein Li 76; unnamed protein product
基因别名: GDH2; GPD2; GPDM; mGDH; mGPDH
UniProt ID: (Human) P43304
Entrez Gene ID: (Human) 2820